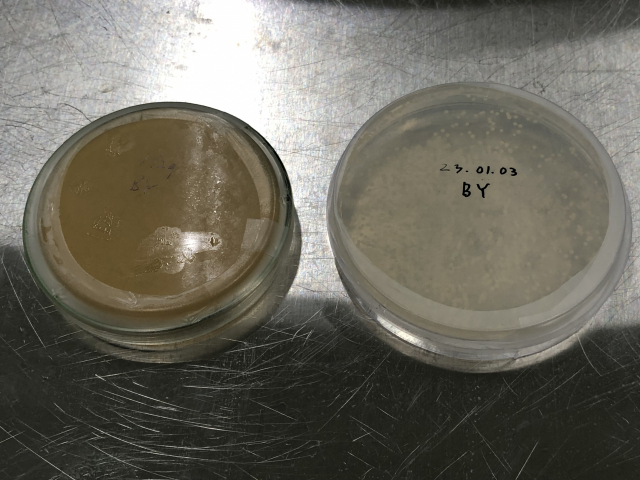

귀농 꿈꾸다 술 연구…달 생각하며 빚은 '일월삼주' [술도락 맛홀릭] <4>
- 가
[술도락 맛홀릭] <4>
함안 '빛올양조연구소'의 '일월삼주'
묵직·상큼…닮은 듯 다른 쌍둥이 술
 일월삼주의 같은 원주로 만든 ‘일주142’(오른쪽)와 ‘이주’. 탁주인 일주를 맑게 여과하면 이주가 된다.
일월삼주의 같은 원주로 만든 ‘일주142’(오른쪽)와 ‘이주’. 탁주인 일주를 맑게 여과하면 이주가 된다.
가가호호 술을 빚던 시절이 있었다. 일제강점기를 거치며 사라졌던 가양주(家釀酒) 문화가 100년 만에 다시 부활하고 있다. 현재까지 발급된 지역특산주 면허만 1400건에 이르고, 해마다 새로운 양조장과 전통주가 탄생한다.
전통주엔 지역의 특색이 오롯이 담겼다. 지역에서 나는 재료로 술을 빚어, 특산음식과도 잘 어울린다. <부산일보>는 ‘술도락 맛홀릭’ 기획시리즈를 통해 부울경의 전통주 양조장을 탐방하며 지역의 맛과 가치를 재조명한다. 이지민 대동여주도 대표 등 전통주 전문가도 힘을 보탠다.

귀농을 꿈꾸던 20대 청년이 있었다. 10년이 흘러 그는 한적한 시골 마을에서 술을 빚는다. 양조를 넘어 전통주 연구에 빠져든 부산 청년을 만나러 경남 함안으로 향했다.
■만화에서 출발해 오기로 도전한 우리 술
함안군 군북면 월촌리 한 도로변에 자리한 샌드위치 패널 건물. 간판 하나 없는 이곳은 김 대표가 홀로 전통주를 연구·개발·생산·유통하고 있는 양조장, 아니 연구소다.
‘빛올’이란 양조장 이름부터 예사롭지 않다. 아침 해처럼 빛이 올라온다는 의미와 오가닉(친환경) 재료를 쓴다는 점을 강조해 김비성(36) 대표가 직접 지었다. 정식 명칭은 ‘빛올양조연구소’. 실제로 김 대표는 연구원처럼 흰색 가운 차림으로 취재진을 맞았다.
“제품을 만들 때 정밀하고 체계적이어야 하잖아요. 추후엔 발효 관련 연구 과제도 수주해 운영할 계획이어서 연구소라고 이름 붙였습니다.”
빛올양조연구소는 효모를 접종·배양하는 시설과 흡광도측정기 등 여느 양조장에는 없는 각종 실험 장비를 갖추고 있다. 대표 사무실을 겸한 공간 명칭도 ‘실험실’이다. 이 실험실은 술이 익어가는 ‘담금실’과 문 하나 사이로 연결된다.
 경남 함안군 군북면 월촌리 마을에 자리한 빛올양조연구소. 김 대표가 아버지와 함께 손수 지은 건물이다. 빛올양조연구소 제공
경남 함안군 군북면 월촌리 마을에 자리한 빛올양조연구소. 김 대표가 아버지와 함께 손수 지은 건물이다. 빛올양조연구소 제공
 빛올양조연구소의 '실험실'. 오른쪽에 놓인 기기가 효모를 접종·배양하는 장비다. 안쪽 창문 너머로 '담금실'과 발효조가 보인다.
빛올양조연구소의 '실험실'. 오른쪽에 놓인 기기가 효모를 접종·배양하는 장비다. 안쪽 창문 너머로 '담금실'과 발효조가 보인다.
김 대표가 우리 술에 입문하게 된 계기부터 흥미롭다. 부산에서 나고 자란 그는 잔병치레가 많아 어린 시절 가족과 함께 경남 등지로 등산을 자주 다녔다. 그렇게 자연과 친해졌고, 자연스럽게 농촌 생활에 관심을 갖게 됐다. 도시 청년으로서 쉽지 않은 결정이었지만 그는 대학을 졸업하기 전부터 체계적으로 귀농 준비를 시작했다.
처음부터 전통주 양조장을 생각했던 건 아니다. 눈을 띄우고 불을 지핀 건 만화였다. “귀농을 하면 음식도 직접 만들어야 하니 한때 모든 관심사가 요리였어요. <식객>이란 만화를 보다 술 만드는 방법이 나오길래 한 번 빚어 봤는데 너무 맛이 없는 겁니다. 그래서 오기가 생겼죠.”
100번이고 200번이고 집에서 술을 빚으며 시행착오를 겪다 전통주 교육기관의 존재를 알게 됐고, 체계적으로 배우면서 우리 술의 매력에 푹 빠졌다. 실패하면 성공할 때까지 계속 도전하는 성격 덕분에 김 대표는 곧 전통주 분야에서 두각을 나타냈다. 아마추어로 참가한 2018년 궁중술빚기 대회에서 장관상을 받는 등 각종 대회에서 수상이 이어졌다.
하지만 양조장을 차리고, 술을 출시하는 건 차원이 다른 일. 부산대 대학원(식품영양학)에서 미생물을 연구하고, 서울을 오가며 전문적인 전통주 교육을 받는 등 수년간 준비하고 또 준비했다. 비용을 아끼려 양조장 건물은 건축일을 하시는 아버지와 함께 손수 지었다. 실험 장비들도 중고로 구하거나 여기저기서 지원을 받아 마련했다.
2021년에야 사업자 등록을 하고, 이듬해 비로소 첫 번째 술이 탄생했다. 귀농을 준비한 지 10년 만에 김 대표의 꿈이 빛을 본 것이다. 빛올의 술이 더 값져 보이는 이유다.
 빛올양조연구소 김비성 대표가 오랜 연구 끝에 개발한 '일월삼주' 시리즈 중 '일주'(탁주)와 '이주'(약주)를 소개하고 있다.
빛올양조연구소 김비성 대표가 오랜 연구 끝에 개발한 '일월삼주' 시리즈 중 '일주'(탁주)와 '이주'(약주)를 소개하고 있다.
 담금실 발효조에서 익어가는 술. 왼쪽부터 발효 이틀, 4주, 6주가 지난 모습이다.
담금실 발효조에서 익어가는 술. 왼쪽부터 발효 이틀, 4주, 6주가 지난 모습이다.
■익어가는 청년의 꿈, 달을 생각하며 빚다
‘일월삼주(一月三舟·하나의 달을 세 배에서 본다)’. 술 이름에서도 고민의 흔적이 엿보인다. 같은 달도 사람에 따라 달리 보이듯, 누룩으로 빚은 술의 다양하고 풍성한 맛의 특징을 이름에 담았다.
“하나의 원주에서 일주(탁주), 이주(약주), 삼주(소주)가 나오는 점도 일월삼주의 의미와 딱 맞아떨어져요. 게다가 이곳 마을 이름도 월촌(月村)이거든요.”
일월삼주는 탁주인 ‘일주142’, 약주인 ‘이주’, 현재 개발 중인 ‘삼주’(소주)까지 모두 3종이다. 일주는 지난해 7월, 이주는 같은 해 10월 출시됐다. 두 술 모두 알코올 도수가 거의 원주에 가까운 14.2도이다.
이주는 일주를 맑게 걸러낸 술이어서 같은 뿌리지만, 향과 맛은 확연히 차이가 난다. 일주는 진한 막걸리 특유의 질감을 보여 준다. 산미도 강해 누룩 막걸리 특유의 맛을 좋아하는 애주가라면 구미가 당길 만하다. 풍성한 과실향과 새콤달콤한 향미를 지닌 이주는 입맛을 돋우는 식전주로 좋다. 일주·이주 모두 높은 알코올 도수에 비해 부드럽게 감기는 맛이다. 다만 연거푸 몇 잔 기울이다 보면 화끈한 알코올 기운이 올라온다.
 김비성 대표가 저온창고에서 숙성 중인 '이주'를 살펴보고 있다.
김비성 대표가 저온창고에서 숙성 중인 '이주'를 살펴보고 있다.
 20대 시절인 2015년, 한 전통주 행사에 참가한 김 대표. 빛올양조연구소 제공
20대 시절인 2015년, 한 전통주 행사에 참가한 김 대표. 빛올양조연구소 제공
일월삼주는 쌀·물·누룩으로만 빚는다. 쌀은 오리농법으로 키운 함안지역 친환경 찹쌀 ‘도란미’를 쓴다. 단양주임에도 세 번, 네 번 빚은 삼양주·사양주 같은 깊이가 있다. 45일이라는 긴 발효 기간에다 직접 배양한 ‘빛올효모’를 넣어 맛의 깊이를 더했다는 게 김 대표의 설명이다. 이주는 일주를 여과한 뒤 한 달 정도 더 숙성을 한다.
“연잎주를 만드는 과정에서 발견한 효모를 배양해서 쓰고 있어요. 누룩도 자가 누룩으로 대체하려고 시도 중이고요. 이주의 경우 여과를 통해 일주의 탁한 부분은 물론 효모까지 걸러내기 때문에 전혀 다른 맛이 납니다.” 차분한 설명 속에서 홀로 연구·실험하며 고군분투했을 시간들이 느껴진다.
아직은 1인 기업이지만, 김 대표의 마음 속엔 더 큰 꿈이 익어가고 있다. 도수가 낮은 7도짜리 탁주를 올해 출시하고, 뒤이어 25도짜리 증류식 소주인 ‘삼주’를 선보일 계획이다. 일월삼주 3종 세트가 완성되면, 함안 특산품인 수박을 활용한 수박 막걸리도 내년쯤 내놓겠단 구상이다.
120평 규모의 양조장 건물 중 현재 사용하는 공간은 절반 정도. 나머지는 김 대표가 펼칠 또 다른 미래를 위해 남겨 뒀다.
“빈 공간을 예쁘게 꾸며서 일반 사람들이 시음도 하고 양조장 견학을 할 수 있게끔 운영하고 싶어요. 그보다 먼저 직원을 둬야 할 정도로 생산(판매)량을 늘리는 게 1차 목표입니다.”
현재 일주와 이주의 월 판매량은 각 1000병 정도. 탁주 못지않게 약주의 판매 비율이 높다. 온라인 쇼핑몰과 보틀숍, 부산지역 일부 주점에서 만나볼 수 있다.
 김비성 대표가 실험실에서 장비를 활용해 작업하고 있다. 빛올양조연구소 제공
김비성 대표가 실험실에서 장비를 활용해 작업하고 있다. 빛올양조연구소 제공
김 대표가 연잎에서 추출해 직접 배양한 '빛올효모'.
김 대표가 연잎에서 추출해 직접 배양한 '빛올효모'.

■일월삼주와 생선구이·소수육이 만나면…
일월삼주는 알코올 도수가 높다 보니 술술 마시기보단 식전주, 혹은 식사와 곁들여 조금씩 음미하길 추천한다. 보통의 탁주·약주처럼 기본적으로 한식과 궁합이 맞는데, 매콤한 음식에는 이주보다 일주가 더 잘 어울린다.
일월삼주와 어울릴 함안지역 맛집 중엔 ‘전원휴게소’란 생선요리 전문점이 있다. 식사 시간대엔 넓은 주차장이 가득 들어찰 정도로 손님이 몰린다. 메뉴는 단출하게 생선(모둠)구이·생선조림·갈치조림 단 3가지. 주인장이 부산과 여수 등지를 돌며 가격대가 맞는 가장 신선한 생선을 공수해 온다고 한다. 모둠구이에는 이주, 칼칼한 양념이 배인 조림에는 일주가 어울린다.
무한리필인 밥과 미역국, 쌈(배추·다시마)에서 시골 밥상의 넉넉한 인심이 느껴진다. 계절별로 10여 가지 생선 중 골라 구워낸 모둠구이는 물론, 미역국에 들어가는 생선도 그때그때 바뀌기 때문에 시기별로 다양한 생선을 맛볼 수 있다. 매일 요리에 쓰인 생선을 화이트 보드에 ‘오늘의 생선’으로 소개한다.
함안과 지척인 의령에는 소고기가 유명하다. 소고기 음식 중에서도 별미인 소수육은 김 대표가 추천하는 조합이다.
일월삼주를 더 맛있게 마시려면 시원하게 보관하길 권한다. 특히 일주는 냉동실에 2시간 정도 넣어 두거나 얼음잔에 부은 뒤 흔들어 마시면 한층 부드럽고 깊은 맛을 즐길 수 있다.
글·사진=이대진 기자 djrhee@busan.com
 경남 함안의 맛집 '정원휴게소'의 대표메뉴인 생선구이와 생선조림·갈치조림(오른쪽 위부터 시계방향).
경남 함안의 맛집 '정원휴게소'의 대표메뉴인 생선구이와 생선조림·갈치조림(오른쪽 위부터 시계방향).
[기자들의 시음평]
▶김희돈 스포츠라이프부 부장
(일주) "허한 속과 취기를 동시에 채우는, 땀 흘리며 모내기 한 뒤 마시는 농주 같은 느낌."
(이주) "매실 원액을 마시는 것처럼 향이 엄청 강하다. 향도 맛도, 압도적인 바디감이다."
▶이상배 디지털미디어부 기자
(일주) "걸쭉하게 새콤하면서 달다. 매실 느낌의 새콤함이 받쳐줘 단맛이 물리지 않는다."
(이주) "매실주 향이 나면서, 뒷맛은 약주의 진한 여운. 젊은 층도 친숙하게 마실 수 있을 듯."
▶이지민 디지털미디어부 에디터
(일주) "맛있는데 세다. 속 안에서 뜨끈뜨끈한 게 느껴진다. 그냥 마시면 훅 갈 것 같은..."
(이주) "새콤한데 끝맛이 살짝 고소하다. 향도 새콤달콤한데, 과일주보다 훨씬 고급스럽다."
▶정윤혁 디지털미디어부 PD
(일주) "진한 막걸리 하면 상상되는 바로 그 느낌. 높은 알코올 도수에 비해 세진 않다"
(이주) "처음엔 독한 느낌이 들다 점점 옅어져 무겁지 않다. 잔향이 입안에 계속 남는다."
[전문가의 맛 코멘트]
▶이지민 대동여주도 대표
(일주) "향에서 새콤한 과실이 떠오른다. 적당히 익은 자두를 깨물었을 때의 새콤함, 청매실의 싱그러움 등과 함께 곡물과 견과류의 구수함이 저변에 은근하게 깔려 있다. 향의 특징이 맛에서도 그대로 이어지는데, 원주에 가까운 농밀함과 곡류의 단맛에 강한 산미가 더해져 맛을 완성한다. 농축미·감칠맛이 강해 입을 자꾸만 다시게 된다. 입맛 없을 때나 더울 때 차갑게 마시면 없던 입맛도 돌아올 것 같다. 대중 막걸리에 익숙한 분들에겐 어려운 맛일 듯. 술꾼들에게 권하고 싶은 막걸리다."
(이주) "막 오픈했을 땐 향이 다소 갇힌 듯하지만 시간이 지날수록 조금씩 깨어난다. 일주에서 느껴진 과실 산미가 전체적인 맛을 형성한다. 단맛보다 산미가 조금 더 강해 술맛을 리드하는 느낌인데, 둘이 탄탄하게 어우러지며 후미까지 쭉 한 몸으로 이어진다. 식전주로 입맛을 돋우는 데 아주 좋을 듯."

-제품명 : 일월삼주 '일주142' / '이주'
-양조장 : 빛올양조연구소(경남 함안군)
-내용량 : 350mL
-알코올 : 14.2%
-원재료 : 쌀·누룩·빛올효모·정제수
이대진 기자 djrhee@busan.com
당신을 위한 추천 기사
실시간 핫뉴스












